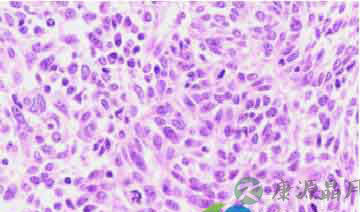
癌症百科：什么是鳞癌？

……
【定义】
简称鳞癌,又称表皮样癌,是发生在皮肤、附属器或粘膜的恶性肿瘤。
【病因】
认为与环境有关,尤其是阳光的刺激有明显关系,长期日光晒曝和慢性刺激是主要发病潜因,外伤、放射线照射、焦油类衍生物亦可诱发本病,盘状红斑狼疮、慢性溃疡、粘膜白斑、烧伤瘀痕及长期不愈的肉肿均可诱发鳞状细胞癌。
【临床表现】
多发于50岁以上的男性,常见于面部、头皮、下唇、手背、前臂、阴部等处。尤其是皮肤与粘膜交界处更易发生。初起为暗红色坚硬的疣样小结节,表面毛细血管扩张,中央有角质物附着,不易剥离,用力剥后可出血。皮损逐渐扩大,形成坚硬的红色斑块,表面有少许鳞屑,边境清楚,向周围浸润,触之较硬,迅速扩大形成溃疡,溃疡向周围及深部侵犯,可深达肌肉与骨骼,损害互相粘连形成坚硬的肿块,不易移动,溃疡基底部为肉红色,有坏死组织,有脓液、臭味,易出血。溃疡边缘隆起外翻,有明显炎症,自觉疼痛。如发生在皮肤与粘膜交界处,固潮湿与摩擦更易出血,发展更快,可形成菜花状,破坏性大,有明显疼痛,易转移,预后不良。
【病理】
表皮角化,肿瘤由鳞状上皮细胞团块所组成,不规则地向真皮内浸润,棘细胞呈瘤性增生,呈条索状或巢状细胞团,边缘以基底细胞层,中心部有角化性癌珠,在癌细胞团内有很多分裂象,周围淋巴细胞和浆细胞浸润。
【诊断】
根据皮损,临床表现,组织病理变化。
【防治】
避免日光照射,积极治疗原发病。

豫公网安备 41110202000246号互联网药品信息服务资格证书:(豫)-经营性-2022-0039增值电信业务经营许可证:豫B2-20221313医疗器械经营备案编号:豫郑食药监械经营备20212188号



